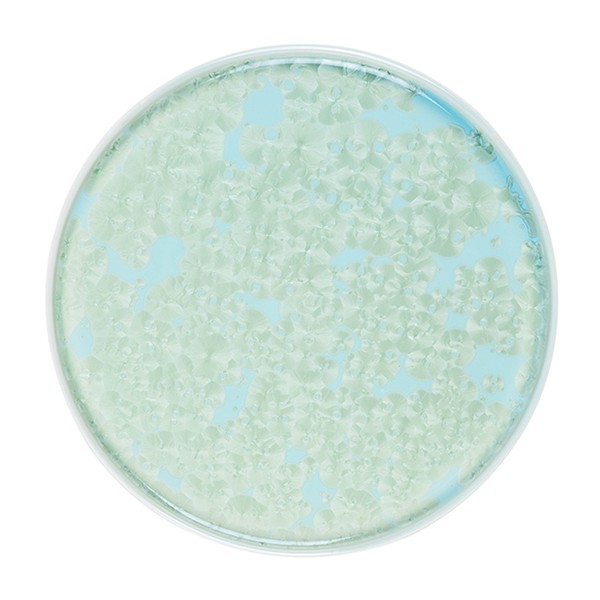

Тарелка «Фрост» с бортом, фарфор, 260 мм, зелёный
2,627.00 р.
2,855.00 р.
-8%
Наличие:
Товар точно есть на складе
Артикул: DC 3015744
Арт. производителя: ZH003-Y191/G
Материал: Фарфор
Группы товаров: Предметы сервировки, Посуда, Профессиональная посуда, Прочие предметы сервировки, Тарелки
Производитель: Royal Charm
Серия: Frost
Страна производителя: Китай
Описание товара
Материал: Фарфор
Производитель: Royal Charm
Серия: Frost (Фрост)
Страна производства: Китай
Цвет: Зеленый
Можно использовать в посудомоечной машине: Нет
Можно использовать в микроволновой печи (СВЧ): Нет
Высота: 1.9 см
Диаметр: 26 см
Вес: 0.849 кг
Категория: Тарелки плоские
Ключевые слова: Тарелка
Производитель: Royal Charm
Серия: Frost (Фрост)
Страна производства: Китай
Цвет: Зеленый
Можно использовать в посудомоечной машине: Нет
Можно использовать в микроволновой печи (СВЧ): Нет
Высота: 1.9 см
Диаметр: 26 см
Вес: 0.849 кг
Категория: Тарелки плоские
Ключевые слова: Тарелка
Блюдо для подачи «Фрост» квадратное, фарфор, 79✕79✕117 мм, зелёный
DC 3025346
1,510.00 р. 1,606.00 р.